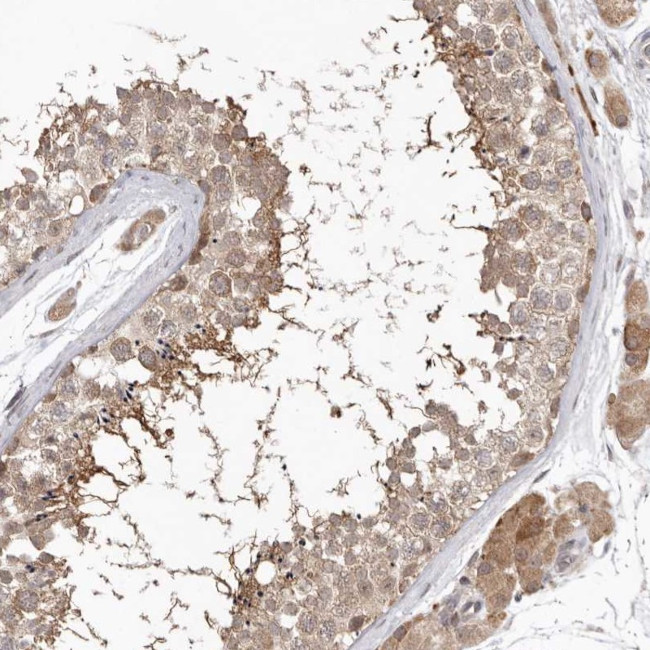
NSUN4 Antibody in Immunohistochemistry (IHC)

Search
Invitrogen
NSUN4 Polyclonal Antibody
{{$productOrderCtrl.translations['antibody.pdp.commerceCard.promotion.promotions']}}
{{$productOrderCtrl.translations['antibody.pdp.commerceCard.promotion.viewpromo']}}
{{$productOrderCtrl.translations['antibody.pdp.commerceCard.promotion.promocode']}}: {{promo.promoCode}} {{promo.promoTitle}} {{promo.promoDescription}}. {{$productOrderCtrl.translations['antibody.pdp.commerceCard.promotion.learnmore']}}
产品信息
PA5-55876
种属反应
宿主/亚型
分类
类型
抗原
偶联物
形式
浓度
规格
纯化类型
保存液
内含物
保存条件
运输条件
RRID
产品详细信息
Immunogen sequence: MAALTLRGVR ELLKRVDLAT VPRRHRYKKK WAATEPKFPA VRLALQNFDM TYSVQFGDLW PSIRVSLLSE QKYGALVNNF AAWDHVSAKL EQLSAKD
Highest antigen sequence identity to the following orthologs: Mouse - 86%, Rat - 86%.
靶标信息
NSUN4 is a 5-methylcytosine rRNA methytransferase that is involved in mitochondiral ribosome assembly. More specifically NSUN4 is involved in mitochondrial ribosome small subunit (SSU) maturation by methylation of mitochondrial 12S rRNA. This function is independent of MTREFD2/MTERF4 and assembled mitochondrial ribosome large subunit (LSU). NSUN4 is targeted to LSU by MTREFD2/MTERF4 and is involved in the final step in ribosome biogenesis to ensure that SSU and LSU are assembled.
仅用于科研。不用于诊断过程。未经明确授权不得转售。
篇参考文献 (0)
生物信息学
蛋白别名: 5-cytosine rRNA methyltransferase NSUN4; 5-cytosine tRNA methyltransferase NSUN4; 5-methylcytosine rRNA methyltransferase NSUN4; 5-methylcytosine tRNA methyltransferase NSUN4; mRNA cytosine C(5)-methyltransferase NSUN4; NOL1/NOP2/Sun domain family member 4; NOP2/Sun domain family, member 4; NOP2/Sun RNA methyltransferase family member 4; putative methyltransferase NSUN4; RP4-603I14.2; sperm head and tail associated protein; unnamed protein product
基因别名: NSUN4; SHTAP
UniProt ID: (Human) Q96CB9
Entrez Gene ID: (Human) 387338